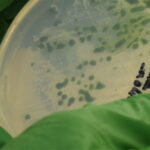
recent algae discovery كيف يمكن للطحالب أن تعزز إنتاج الوقود الحيوي؟ مجلة نقطة العلمية

تم زرع كليتين من كلى الخنازير المعدلة وراثيًا بنجاح في متلقي بشري ميت دماغيا، مما يثبت لأول مرة أنه يمكن تكييف كلى غير بشرية لاستخدامها في المرضى الذين يحتاجون إلى عملية زرع.
يقول الفريق في جامعة ألاباما، برمنغهام، إنهم يستعدون لتجربة سريرية تشمل متلقين بشريين أحياء،
لمعرفة ما إذا كان هذا النهج حلا محتملا للنقص الحالي في أعضاء الزرع المتاحة.
يُطلق على وضع أعضاء غير بشرية في المتلقين من البشر اسم “زرع الأعضاء الخارجية”،
وقد تم إثبات ذلك بالفعل في تجربتين سابقتين على كلى الخنازير.
ومع ذلك، كتب الباحثون وراء هذه الدراسة الأخيرة، في المجلة الأمريكية للزراعة، أن دراستهم هي الأولى من نوعها
التي تستخدم عضوا من الدرجة السريرية مناسب للاستخدام العلاجي المباشر في المرضى الأحياء.
تتمحور إحدى أكبر العوائق أمام زرع الأعضاء الخارجية حول حقيقة أن أجهزتنا المناعية مهيأة للتعرف على المواد الغريبة ورفضها.
للتغلب على هذا، استخدمت التجارب السابقة كلى الخنازير المعدلة وراثيًا تفتقر إلى جزيء السكر المسمى alpha-gal،
الموجود على سطح أعضاء الخنازير ويمكن التعرف عليه بسهولة من قبل جسم الإنسان.
في حين أن هذا منع رفض الكلى لمدة تصل إلى 54 ساعة، فقد قام الباحثون الآن بتحسين هذا النهج من خلال إدخال عشرة تعديلات جينية مختلفة في الأعضاء،
على غرار الطريقة التي تم بها تعديل قلب الخنزير مؤخرًا للزرع في الإنسان.
أدت هذه التعديلات إلى فقدان ثلاثة مستضدات كربوهيدرات الخنازير بالإضافة إلى جين مستقبل هرمون نمو الخنازير.
نجاح عملية زرع كليتين من خنزير معدل وراثيا يوفر أملا جديدا لمرضى الكلى
بالإضافة إلى ذلك، تم إدخال عدد من الجينات البشرية المضادة للتخثر والجينات المنظمة للمناعة، مما يجعل الكلى أكثر توافقًا مع جسم الإنسان.
تم زرع الكلى المعدلة في مريض ميت دماغياً يبلغ من العمر 57 عامًا يدعى جيم بارسونز، ومنحت عائلته الأطباء الإذن بإجراء العملية بعد تعرضه لحادث دراجة نارية.
وفقًا لمؤلفي الدراسة، لم يرفض جسم المريض الأعضاء وظلت قابلة للحياة لمدة 77 ساعة كاملة.
إقرأ أيضا:
هل يعيش الإنسان بكلية واحدة .. هذه الدراسة تطلعكم على التفاصيل
والأهم من ذلك، أشاروا أيضًا إلى أن الأوعية الدموية في الكلى كانت قادرة على تحمل ضغط الدم البشري بنجاح،
وهو أعلى بكثير من ضغط الخنازير، ولم يتم اكتشاف خلايا أو فيروسات خنزير في دم بارسونز.
في النهاية، كان الغرض من هذه الدراسة هو تطوير نموذج ما قبل السريرية لزرع الأعضاء لاختبار سلامة وجدوى هذا النهج،
وبالتالي تمهيد الطريق للتجارب السريرية المستقبلية.
لم تكن الفكرة، إذن، لتحسين وظائف الكلى، ومع ذلك كان الباحثون قادرين على تأكيد أن إخراج البول كان “قويًا” من الكلية اليمنى، وإن كان أقل من اليسار.
أوضح الجراح الرئيسي جايمي لوك في بيان: “تحولت الكلية إلى لفون وردي جميل، وفي غضون 23 دقيقة، بدأت في إنتاج البول”.
لا يزال هناك طريق طويل لنقطعه قبل أن يتم تطبيق زرع الأعضاء على المرضى الفعليين،
ومع ذلك يأمل الباحثون أن يؤدي عملهم يومًا ما إلى زيادة كبيرة في توافر الأعضاء المنقذة للحياة.
وقال لوك: “إن مفهوم القدرة على الحصول على عضو فعليًا ينتظر الشخص الذي يحتاجه، أمر محير للغاية للتفكير فيه، ومثير بالنسبة لهم”.
وأضافت جولي أوهارا، زوجة بارسونز السابقة:
“كان جيم يريد إنقاذ أكبر عدد ممكن من الناس بموته، وإذا كان يعلم أنه من المحتمل أن ينقذ الآلاف والآلاف من الناس من خلال القيام بذلك، فلن يتردد . ”
“حلمنا هو ألا يموت أي شخص آخر في انتظار كلية، ونحن نعلم أن جيم فخور جدًا بأن موته قد يجلب الكثير من الأمل للآخرين.”